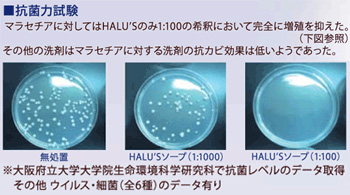

ハルズ プロフェッショナルソープ

ハルズ プロフェッショナルソープ
- 販売価格(税込)
300ml 4014円 ハルズプロフェッショナルシャンプー
美しい被毛は地肌ケアから始める国内初、抗菌データを取得している無添加せっけんシャンプー
ケン化釜炊き製法で1週間から10日かけて、じっくり高品質の安心シャンプーを製造しています【ハルズシャンプーの特徴】
① 無添加シャンプー(合成界面活性剤/酸化防止剤 一切不使用)
② 洗浄力抜群(従来の無添加シャンプーのデメリットをクリア)
③ 泡立ち・泡切れが非常に良い(トリミング初心者でも簡単に使える)
④ 除菌の出来るシャンプー(大阪府立大学で研究データを取得) ※業界初
⑤ 地肌コンディションを整える
⑥ 幼犬から老犬まで使用できる
⑦ 皮膚病、脂性、フケが出る、体臭がきつい子は特にお勧め
⑧ 目に入っても角膜を傷つけない
⑨ 薬用シャンプーの代品として使用可能
⑩ トリマーさんの手にも非常に優しい
※ 使い始め、シャンプーを洗い流すときにキュッキュとして違和感がありますが、被毛を痛めているわけではありませんので、ご安心ください。 続けてご利用いただくことで、地肌状態が安定し、キシみは軽減されていきます。(子犬時期から使用されている場合は上記のようなキシみはほとんどありません)【特におすすめ】
マラセチア除菌・真菌除菌・その他皮膚トラブル
乾燥肌・フケの多いペットには薄めてご利用いただくことをお勧め致します。HALU’Sソープは、セッケン、酵素水、ホホバオイルだけを原料とし、皮膚・被毛に非常にやさしく、肌の弱い人・ペットにも安心してお使いいただけます。
洗浄力の秘密は“特殊製法”にあります。
従来の天然・無添加シャンプーは、合成界面活性剤を使わずに製造すると泡立ちが悪く、洗浄力に欠けるというデメリットがありました。HALU’Sは、釜炊き法でじっくり炊き上げ、セッケン本来の洗浄力を発揮しています。
水・カリ石けん素地・石けん素地・酵素水